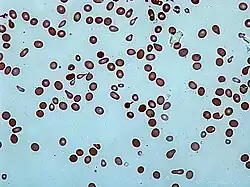
Ilustracja

Poikilocytoza
| Poikilocytosis | |
Zniekształcone erytrocyty – poikilocyty. | |
| Klasyfikacje | |
| ICD-10 |
R71 |
|---|---|
Poikilocytoza – występowanie we krwi silnie zniekształconych krwinek czerwonych[1]. Występuje ona między innymi w niedokrwistości hemolitycznej i Addisona-Biermera[2], u chorych na ostrą niewydolność nerek, mocznicę, mielofibrozę[3], nowotwory złośliwe[4] i dziedziczną pyropoikilocytozę oraz eliptocytozę[5][6][1].
Przypisy
- 1 2 Donald I. Galen, William H. Kern, Poikilocytosis in Cancer Patients, „California Medicine”, 106 (6), 1967, s. 447–449, ISSN 0008-1264, PMID: 6045473, PMCID: PMC1502688 [dostęp 2017-12-03].
- ↑ James A. Hall i inni, B12 deficiency leading to marked poikilocytosis versus true schistocytosis, a pernicious problem, „Transfusion and Apheresis Science: Official Journal of the World Apheresis Association: Official Journal of the European Society for Haemapheresis”, 56 (4), 2017, s. 576–577, DOI: 10.1016/j.transci.2017.06.003, ISSN 1473-0502, PMID: 28711333 [dostęp 2017-12-03].
- ↑ Vinod Pullarkat i inni, Primary autoimmune myelofibrosis: definition of a distinct clinicopathologic syndrome, „American Journal of Hematology”, 72 (1), 2003, s. 8–12, DOI: 10.1002/ajh.10258, ISSN 0361-8609, PMID: 12508261 [dostęp 2017-12-03].
- ↑ J. Forshaw, L. Harwood, Poikilocytosis associated with carcinoma, „Archives of Internal Medicine”, 117 (2), 1966, s. 203–205, ISSN 0003-9926, PMID: 5901551 [dostęp 2017-12-03].
- ↑ F. Gretillat, N. Delepine, J.C. Desbois, [Hereditary elliptocytosis with transient poikilocytosis in children], „Presse Medicale (Paris, France: 1983)”, 12 (44), 1983, s. 2823, ISSN 0755-4982, PMID: 6228858 [dostęp 2017-12-03].
- ↑ F. Lorenzo i inni, Severe poikilocytosis associated with a de novo alpha 28 Arg-->Cys mutation in spectrin, „British Journal of Haematology”, 83 (1), 1993, s. 152–157, ISSN 0007-1048, PMID: 8435324 [dostęp 2017-12-03].
![]() Przeczytaj ostrzeżenie dotyczące informacji medycznych i pokrewnych zamieszczonych w Wikipedii.
Przeczytaj ostrzeżenie dotyczące informacji medycznych i pokrewnych zamieszczonych w Wikipedii.